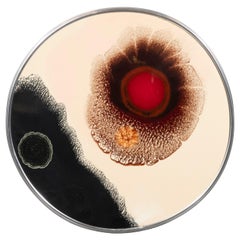
Stop, Look and Listen

By John Moyers
Located in Denver, CO
The Rainy Season, original signed oil painting by western artist, John Moyers, with three Native Americans on horseback in a southwestern desert landscape with blue sky and storm clouds. Painted in colors of golden yellow, blue, white, brown, green, beige, tan and purple. Presented in a custom hand carved gold leaf frame, outer dimensions measure 37 ½ x 31 ½ x 2 ½ inches. Image size is 30 x 24 inches.
Provenance: Private Collection, Colorado
John Moyers is a renowned plein air painter and sculptor known for his southwestern landscape paintings...
Category
21st Century and Contemporary American Impressionist John Moyers Art